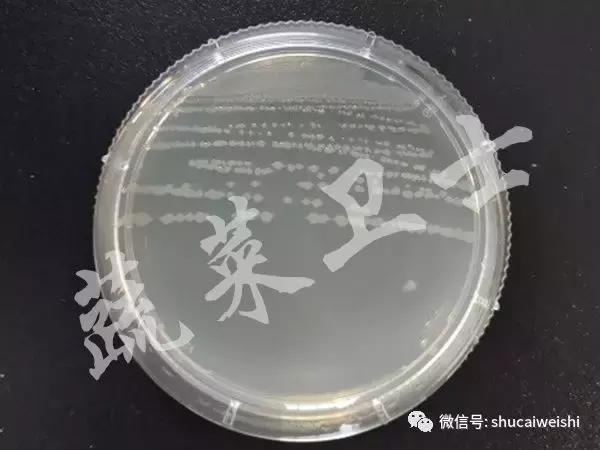
番茄细菌性斑点特别严重怎么办,番茄细菌性髓部坏死病和溃疡病

近期,四川省某地菜农在田间番茄上发现黄褐色斑点,并出现大面积的叶片干枯,于是向我们紧急求助,我们通过显微镜诊断、病原菌分离培养以及分子检测对其进行了准确鉴定。
一 、田间发病症状
茎杆感病,初期产生黑色斑点,病斑周围无黄色晕圈,后逐渐扩大,病斑易连成斑块,严重时可使部分茎部变黑。叶片感病,初期产生深褐至黑色不规则斑点,斑点周围伴有黄色晕圈,后期连接成片,最终枝条干枯。果实近成熟时病斑周围往往保持较长时间的绿色,病斑附近果肉略凹陷,病斑周围黑色,中间色浅并有轻微凹陷。


图1 田间发病症状
二、实验室检测结合田间诊断,确诊病害
我们对该病样叶片发病部位进行显微镜检查,发现有明显的菌溢现象,未发现有其他真菌孢子(图2)。同时提取病样组织DNA,然后利用细菌性斑点病的特异性引物进行PCR检测,确认引起该病的病原菌为丁香假单胞杆菌番茄致病变种(Pseudomonas sringae pv. tomato)(图4)。通过以上检测结果并结合田间症状,将该病害鉴定为番茄细菌性斑点病。
病原菌:该病原菌革兰氏染色为阴性,无荚膜,无芽孢;菌体杆状,直立或稍弯,大小为(0.5~1.0)μm×(1.5~5.0)μm,单细胞,有1至数根鞭毛,在NA培养基上菌落无色透明(图3)。

图2 显微镜观察-菌溢现象

图4 番茄细菌性斑点病特异性引物PCR检测结果
番茄细菌性斑点病特异性引物为BW_F/BW_R;M:BM5000 DNA Marker;1:FQ19062402;2:FQ19062402;P:阳性对照;N:阴性对照
三、引发番茄细菌性斑点病的原因
1、种子带菌引起幼苗染病
从发病果实中收集种子,致使种子表面带菌,或侵染健康种子,使种子内部带菌。该病原菌在干燥的种子上可存活 20 年,可随种子远距离传播。在条件适宜时,少量带菌种子能引发大量幼苗染病。
2、土壤带菌造成病原菌积累
番茄细菌性斑点病的病原菌可在土壤中存活至少 7个月,成为第二年初侵染源,当土壤营养不合理及温湿度相对较高时,病原菌可大量繁殖,引起幼苗发病。
3、温暖高湿的环境,有利于细菌性斑点病的侵染、传播
温度偏低、多雨,地块处在地势低洼、排水不良,关棚时间过长,浇大水等容易造成病害流行。
4、田间管理不善,加重了病原菌的扩展和蔓延
植株发病后,未及时拔除病株,或将病残体任意堆放,未及时清理出园,导致健康植株染病。此外,病原菌粘附在工作服或操作工具上,也能传播到健康番茄植株上,条件适宜时侵染。
四、综合防治措施
1、种子消毒,较少初侵染源
对于种子表面的病原菌,可先用冷水浸湿种子,再将种子放入 55℃的温水浸泡 30 min,或选用 1.05% 的次氯酸钠溶液浸种 20~30 min,或选用 3% 的中生菌素可湿性粉剂 600~800 倍液浸种 30 min,清洗干净后播种。对于种子内部的病原菌,可以采取干热灭菌的方法,注意干热灭菌的温度和时间,并进行小规模试验后,再进行推广应用。
2、土壤处理,减少菌源
育苗尽量选用新苗床或用营养土育苗。每平方米旧苗床用 3% 的中生菌素 5 g/m2,兑水 4~5 kg 浇施。夏天可进行闷棚处理,棚内土壤灌足水后覆膜,高温下晒 4~6 周;或者在定植前 1个月,用42%的威百亩水剂或50%的氰氨化钙颗粒剂对土壤进行熏蒸处理。应用土壤消毒剂,应该遵守技术操作规范。
3、田间管理,不容忽视
严格控制棚内或田间的湿度;田间湿度大时,尽量避免进行整枝、打杈等农事操作;工作服和操作工具可用75% 的酒精进行喷雾消毒;田间发现病株,应立即清除,收获后及时清除田间病残体及周围杂草,并在田外进行深埋,减少翌年的初侵染源。
4、科学用药,高效防控
发病初期及时施药,常用的药剂有 77% 的氢氧化铜可湿性粉剂 800倍液,或 50%的春雷王铜可湿性粉剂 1200倍液,或3%的中生菌素可湿性粉剂500倍液,或大棚蔬菜使用精量电动弥粉机配合格瑞微粉5号药30 g/亩进行防治。田间施药时,铜制剂应与其他药剂轮换使用,防治效果会更好,且避免抗药性的产生。
作者:李新宇,陈利达